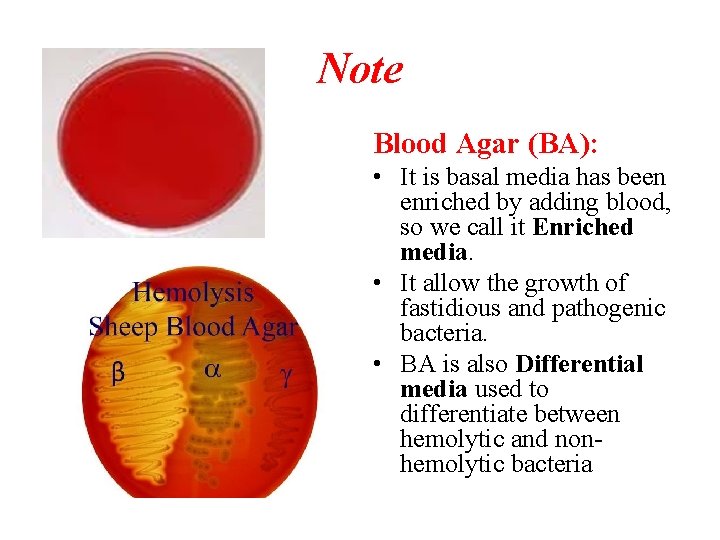
Note Blood Agar (BA): • It is basal media has been enriched by adding
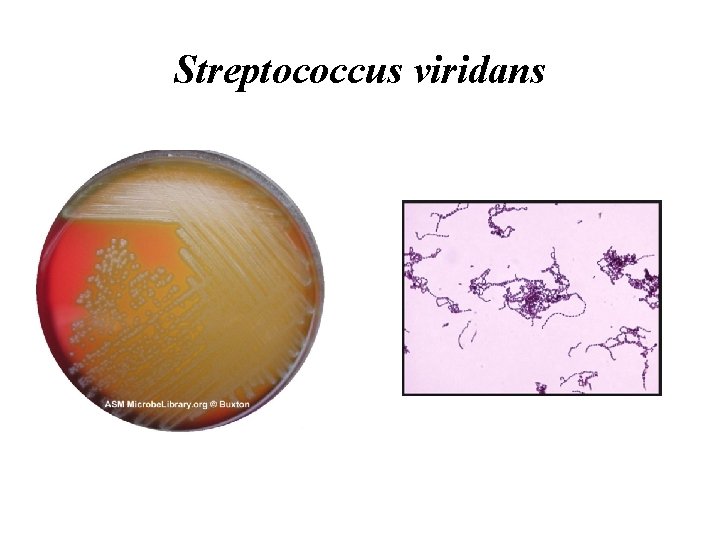
Streptococcus viridans
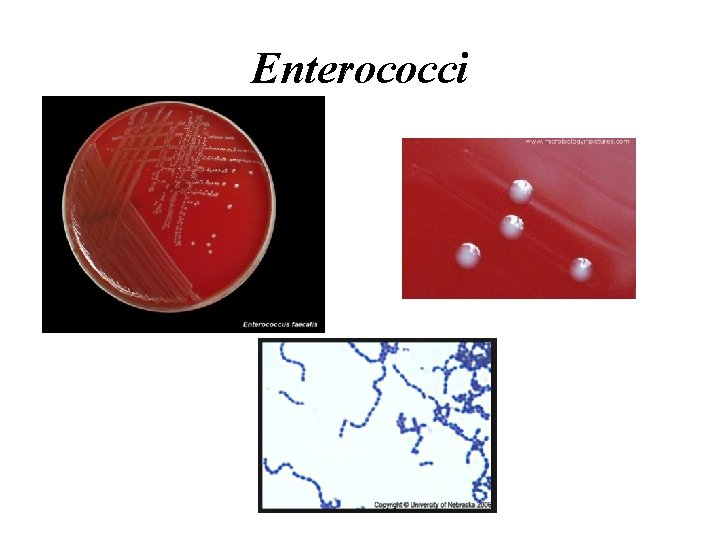
Enterococci

Streptococci Corynebacteria Streptococci Cocci spherical Morphology Gram positive

Streptococci & Corynebacteria

Streptococci Ø Cocci: spherical Morphology: Gram positive, cocci in chains

Characteristics of Streptococci 1. Morphology>> • Gram positive, cocci • Arranged in chains, and some spp. arranged in pairs 2. Habitat>> • Usually found as a normal flora in throat 3. Culture>> • They are Facultative anaerobic • Because of their complex nutritional requirements, blood enriched medium is generally used for their isolation. 4. Biochemical Reactions>> • Catalase negative (don’t produce catalase enzyme) 5. Non- motile
Note Blood Agar (BA): • It is basal media has been enriched by adding blood, so we call it Enriched media. • It allow the growth of fastidious and pathogenic bacteria. • BA is also Differential media used to differentiate between hemolytic and nonhemolytic bacteria

Classification of Streptococci are classified by several schemes: A) Hemolytic properties on blood agar>> Ø α-hemolytic: S. viridance & S. pneumoniae Ø β-hemolytic: S. pyogenes S. agalactia Ø γ-hemolytic: Enterococci spp. B) Serologic (Lancefields) groupings>> Ø Used for the classification of Beta- hemolytic streptococci to: group A (S. pyogenes), group B (S. agalactia), group D, ………. . group V

Alpha-Hemolytic Streptococci There are mainly 2 clinically important species: 1. Streptococcus viridans 2. Streptococcus pneumoniae

1. Streptococcus viridans • Part of the oral and throat flora, mostly a-virulent • Streptococcus mutans is member of the viridancs group that cause dental caries. • S. viridans can cause infection (strep throat)>> rheumatic fever>> Rheumatic Heart Disease (RHD) • In RHD they infect heart valves>> heat failure and death. • At risk patients should receive prophylactic penicillin before undergoing dental procedures.
Streptococcus viridans

2. Streptococcus pneumoniae Gram positive diplococci Colonies appear alpha hemolytic on blood agar plate. Colonies shoes glistening appearance because of the presence of capsule.

S. pneumoniae Infection Ø Bacterial pneumonia Leading cause of death especially in older adults Ø Bacteremia Ø Meningitis Ø Otitis media (middle ear infections) Ø Sinusitis

S. pneumoniae and Eye Infections 1. It causes Hypopyon corneal ulcer. • It is a disk-shaped central corneal ulcer with hypopyon. • Hypopyon>> is inflammatory cells in the anterior chamber of the eye with sterile pus (yellowish exudate) • Perforation secondary to ulcer is common 2. Acute muco-purulent conjunctivitis. 3. Purulent conjunctivitis of the new born.

Risk Factors • Compromised corneal epithelial integrity caused by contact lens wear, corneal trauma, or corneal surgery. • Inappropriate use of topical antibiotics could eliminate the natural protection by the normal flora, this can predispose cornea to develop opportunistic infections, particularly when combined with corneal disease or trauma. • Trauma, including chemical & thermal injuries. • Contact lenses users have 1. 5% chance of developing infectious keratitis.

Beta-Hemolytic Streptococci The most important spp. in this genus are Group A, and B Streptococci 1. S. pyogenes (Group A Streptococci) • Part of throat flora, does not survive well in the environment. • It can spread person to person via skin contact and via respiratory tract. S. pyogenes Infections: Ø Usually cause throat infections (strep throat) or (acute pharyngitis) which is associated with purulent inflammation.

Ø Nasopharyngeal carriage is common especially in colder months and particularly among children. Ø One of the member of this species can cause necrotizing fasciitis (flesh eating bacteria) Ø Scarlet fever: sunburn-like rash may develops on the neck, trunk, and extremities in response to the release of pyrogenic exotoxin. Complications include: • Acute rheumatic fever>> 2 -3 weeks after the initiation of pharyngitis. Characterized by fever, rash, carditis and arthritis. • Acute glomerulonephritis, rare, occur as soon as 1 week after pharyngitis.

Scarlet fever Streptococcal pharyngitis

2. S. agalactiae (Group B Streptococci) • It is found in the vaginocervical tract of female carriers, urethral of male carriers as well as GI tract. • Can be transmitted sexually and from infected mother to her infant at birth. • • It is a leading cause of meningitis and septicemia in neonates, with a high mortality rate.

Non-Hemolytic Streptococci Group D streptococci or Enterococci • They are not very virulent but are important cause of nosocomial infections, especially that they have developed multiple antibiotic resistance. • They are part of the fecal normal flora. • They can also colonies skin and mucous membranes especially in hospital setting. • Not like other Streptococci they are highly resistant to environmental and chemical agents and can persist on non living objects. • Vancomycin resistant Enterococci is a major concern in hospitals.
Enterococci

Corynebacteria

Corynbacteria diphtheriae Characteristics: 1. Morphology>> • Small gram positive rods • Chinese letter pattern, angular arrangement. 2. Culture>> aerobic 3. Biochemical reactions>> Catalase +ve (like staphylococcus). 4. non-spore-forming. 5. Non-motile.

6. Un-capsulated. 7. Not considered part of the normal flora. 8. They cause diphtheria>> • Acute respiratory or cutaneous disease that maybe life threatening. 9. It is found in the throat and nasopharynx of carriers and in patient with diphtheria. 10. It has a very strong single exotoxin that inhibits protein synthesis. 11. It is heat-labile. Antitoxin is available & used in treatment.

C. diphtheria Infection Disease can represent in tow forms: Upper respiratory tract infection>> Ø Localized infection (usually the throat). Ø There is a distinctive thick, grayish, adherent pseudomembrane that coats the throat. Ø Disease progress and generalized symptoms occur due to toxin. Ø Mainly affect heart and peripheral nerves. Cutaneous diphtheria>> Ø C. diphtheria can gain entry to subcutaneous tissue via wound or cut in the skin. Ø It leads to a chronic , non healing ulcer with a gray membrane.


C. diphtheria & Eye Infections It can cause acute membranous conjunctivitis • It is an acute inflammation of the conjunctiva, characterized by formation of a true membrane on the conjunctiva. • Now-a-days it is of very rare occurrence, because of markedly decreased incidence of diphtheria. • It is because of the fact that immunization against diptheria is very effective.

Immunity to C. diphtheria • Children should get 5 doses of DTP vaccine, one dose at each of the following ages: 2 months, 4 months, 6 months, 18 months, 4 to 6 years. • DPT= combination vaccines against three infectious diseases in humans: diphtheria, pertussis, and tetanus • The vaccine components include the bacterial toxoid>> a chemically modified toxin from a pathogenic microorganism, which is no longer toxic but is still antigenic and can be used as a vaccine

Treatment of C. diphtheria • Anti-toxin. • Passive immunization with preformed diphtheria toxin antibodies. • It is sensitive to many antibiotics including penicillin. • Patient must be isolated because the disease is highly contagious

C. diphtheroids • They are morphologically similar to C. diphtheriae but the are not pathogenic. • They live in nose, throat, nasopharynx , skin, urogenital tract and conjunctiva. • They do not produce exotoxin. • May rarely cause disease in the immunocompromized.
- Slides: 27